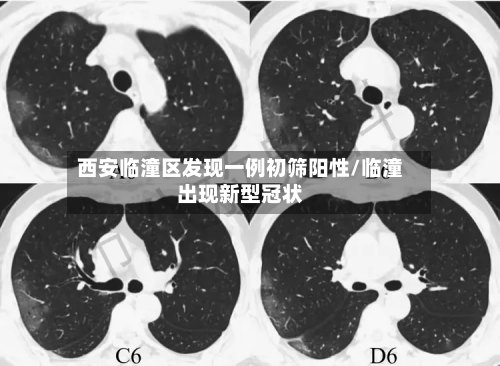
西安临潼区发现一例初筛阳性/临潼出现新型冠状

社会观察
-
上海疫情仍高位运行/疫情,上海
2022年4月13日,上海半城封控的第十七天通过社区互助、资源共享等方式缓解局部物资紧张问题。总结:2022年4月13日的上海处于封控关键期,社区团购成为民生保障核心,但需警惕传播与公平问题;疫情数据反映奥密克戎的挑战性,防疫策略或需针对...
-
【川崎250sl费用,川崎250车型】
川崎摩托车的创始人是谁川崎摩托车的创始人是川崎正藏,他是川崎公司的创始人,其英文名为KAWASAKI。川崎公司最早是一家造船厂,在二战后正式进入摩托车领域,最初以制造摩托车发动机为主。川崎进入摩托车整车制造是在收购明发工业株式会社之后,明...
-
svw车型/svw车型报价
斯科达svw71415el是什么车型斯科达svw71415el对应的车型是上汽大众斯柯达明锐2015款4TSIDSG逸尊版,部分地区可能标为逸俊版。车辆型号svw7147wld是什么车车辆型号SVW7147WLD对应的车型是上海大众牌...
-
西安临潼区发现一例初筛阳性/临潼出现新型冠状
西安有多少粒〖壹〗、例如,2024年4月4日,西安市花粉浓度曾达到4690粒/1000平方毫米,过敏风险等级极高,提示春季树木花粉的致敏风险不容忽视。花粉浓度预测与影响花粉浓度受季节和天气共同影响。秋季天气转凉时,蒿草花粉浓度反而上升;春...
-
主卧室窗子和门一个方向(卧室窗户和门在一边怎么装修)
卧室门对窗户好不好?房间门是对着窗,其实这个从风水方面来讲是不好的,甚至还有可能触犯了一些禁忌。房间门对窗—位置设定以理气向阳见水为准。在房屋风水之中,门和窗的位置如果是设置在正东方位的话,对房屋风水是十分有利的。这是因为正东方位在风水中...
-
92号汽油费用/92号汽油费用今日多少钱一升
现在92汽油多少钱一升大连地区当前92号汽油费用为69元/升该费用自2026年3月24日零时起正式执行,较调价前每升上调0.95元。此次调整依据世界市场油价变化及国内成品油费用机制(每10个工作日调整一次)进行,属于同步调价范畴。重庆9...
-
北京18天内新增318例/北京新增18日
31省区市新增本土病例318+1567〖壹〗、月1日0—24时,31个省(自治区、直辖市)和新疆生产建设兵团新增本土确诊病例318例,新增本土无症状感染者1567例。具体数据及分析如下:新增本土确诊病例318例分布省份:涉及四川、广东、...
-
【香河疫情,香河疫情管控】
11月21日香河县新增4例无症状感染者(香河疑似病例)〖壹〗、月21日,香河县发现4例核酸检测阳性人员,近来正在定点医疗机构隔离治疗,已诊断为无症状感染者,其行动轨迹主要涉及以下风险点位:11月15日—11月20日,新开社区天琴湾二期16...
-
沃尔沃s60新款费用/沃尔沃s60费用2021款
沃尔沃S60:比较高优惠6万多,该纠结买奥迪A4L吗?〖壹〗、奥迪A4L:后期保养费用相对沃尔沃S60可能会高一些,具体费用因保养项目和地区而异,但总体来说在豪华品牌中属于中等水平。二手车残值沃尔沃S60:以2020款T4智逸豪华版为...
-
河南昨日新增本土确诊68例(河南昨日新增24例)
中国疫情如何〖壹〗、中国成功使国内疫情好转,是多方面因素协同作用的结果,具体如下:果断而迅速的早期反应疫情初期,中国政府迅速确认病毒人传人风险,果断采取“武汉封城”措施,有效阻断病毒向全国扩散,为其他地区争取了宝贵的准备时间。〖贰〗、国内...